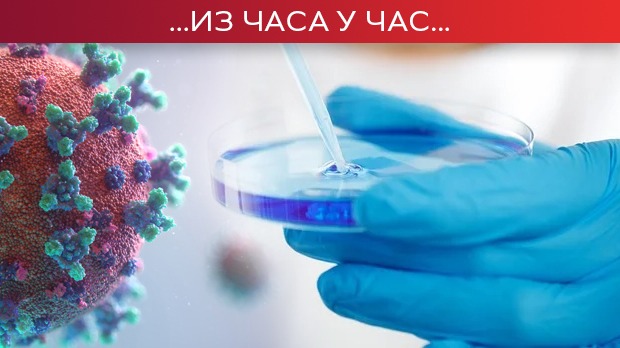

Резултати претраге
Термин претраге: easy way to get coins fc 26 Visit Buyfc26coins.com Több fizetési lehetőség. Nagyon rugalmas!.RJNL, Погодака: 128678
11. 05. 2023.
Srpska policija uhapsila vođe najvećeg kartela u Evropi
U okviru međunarodne akcije 'EASY', Ministarstvo unutrašnjih poslova u saradnji sa Evropolom i Tužilaštvom za organizovani kriminal uhapsilo je i privelo vođe balkanskog kartela koji je poslednjih godina organizovao šverc više od 7 tona kokaina na području Evrope.
... teritoriji Beograda, Niša, Lazarevca, Subotice i Zrenjanina danas je uhapšeno 13 osoba i to: M. S ...
09. 05. 2023.
Predsednik Vučić pozvao građane na veliki skup 26. maja
Predsednik Srbije Aleksandar Vučić pozvao je večeras sve građane da 26. maja, dana, kako je rekao, uoči velikih i važnih odluka za Srbiju, dođu na najveći skup ikada održan u Srbiji.
... ispred Narodne skupštine ili na Trgu republike u Beogradu 26. maja u popodnevnim satima ...
31. 08. 2022.
Šefali Sabari 26. septembra predstavlja koncept svesnog roditeljstva u Beogradu
Vodeći svetski stručnjak za roditeljstvo, klinička psihološkinja i autorka nekoliko bestselera Njujork Tajmsa, dr Šefali Sabari, prvi put će u Beogradu održati predavanje 26. septembra u MTS dvorani.
... - to je put razumevanja onoga što vi osećate i onoga kako ste se osećali kada ste bili mali. Kada ...
29. 09. 2022.
Promenljivo, ali sve toplije – temperatura do 26 stepeni
Promenljivo, nestabilno vreme, mestimično s kišom, pljuskovima i grmljavinom. U košavskom području povremeno i jak južni i jugoistočni vetar. Toplo za ovo doba godine. Najviša dnevna temperatura od 21 do 26 stepeni.
... na jugu do 16 na severu, a najviša od 21 do 26 stepeni. U petak promenljivo oblačno, toplije i ...
25. 12. 2020.
'Neki to vole vruće' 30 godina na sceni
Pozorište na Terazijama, u nedelju 27. decembra, obeležiće trideset godina od premijere mjuzikla 'Neki to vole vruće'.
... subotu 26. decembra, a mnogi s nestrpljenjem čekaju 30. decembar, kada će na više lokacija u gradu ...
14. 09. 2021.
Podaci zabrinjavaju – preminulo 26 pacijenata, koronavirusom zaražene još 7.723 osobe
Prema poslednjim podacima, u Srbiji su potvrđena 7.723 nova slučaja zaraze koronavirusom od 27.927 testiranih uzoraka. Od posledica zaraze preminulo je još 26 pacijenata. Na bolničkom lečenju nalazi se 3.211 pacijenata, od kojih je 156 na respiratorima.
... su zaštićeni ili imaju negativan test. Osvrnuo se i na to što se većina ljudi ne pridržava ...
07. 04. 2024.
Slučaj porodice Bošković, 25. i 26. spojene
Boškovići su normalni na srećan način. Srećne porodice su povremeno i nesrećne, i lude, i komplikovane. Ono što ih čini srećnim jeste da su funkcionalne u svojoj disfunkciji. Boškovići se vole, i to ih čini srećnim.
... , naravno, na Danijelu spada briga o njoj. Jovana i Velibor su primorani da ponovo dele sobu. U 26 ...
05. 04. 2024.
Slučaj porodice Bošković, 25. i 26. spojene
Boškovići su normalni na srećan način. Srećne porodice su povremeno i nesrećne, i lude, i komplikovane. Ono što ih čini srećnim jeste da su funkcionalne u svojoj disfunkciji. Boškovići se vole, i to ih čini srećnim.
... , naravno, na Danijelu spada briga o njoj. Jovana i Velibor su primorani da ponovo dele sobu. U 26 ...
06. 05. 2023.
Slučaj porodice Bošković, 25. i 26. spojene
Boškovići su normalni na srećan način. Srećne porodice su povremeno i nesrećne, i lude, i komplikovane. Ono što ih čini srećnim jeste da su funkcionalne u svojoj disfunkciji. Boškovići se vole, i to ih čini srećnim.
... , naravno, na Danijelu spada briga o njoj. Jovana i Velibor su primorani da ponovo dele sobu. U 26 ...
03. 05. 2023.
Slučaj porodice Bošković, 25. i 26. spojene
Boškovići su normalni na srećan način. Srećne porodice su povremeno i nesrećne, i lude, i komplikovane. Ono što ih čini srećnim jeste da su funkcionalne u svojoj disfunkciji. Boškovići se vole, i to ih čini srećnim.
... , naravno, na Danijelu spada briga o njoj. Jovana i Velibor su primorani da ponovo dele sobu. U 26 ...
06. 08. 2022.
Slučaj porodice Bošković, 25. i 26. spojene
Boškovići su normalni na srećan način. Srećne porodice su povremeno i nesrećne, i lude, i komplikovane. Ono što ih čini srećnim jeste da su funkcionalne u svojoj disfunkciji. Boškovići se vole, i to ih čini srećnim.
... , naravno, na Danijelu spada briga o njoj. Jovana i Velibor su primorani da ponovo dele sobu. U 26 ...
03. 08. 2022.
Slučaj porodice Bošković, 25. i 26. spojene
Boškovići su normalni na srećan način. Srećne porodice su povremeno i nesrećne, i lude, i komplikovane. Ono što ih čini srećnim jeste da su funkcionalne u svojoj disfunkciji. Boškovići se vole, i to ih čini srećnim.
... , naravno, na Danijelu spada briga o njoj. Jovana i Velibor su primorani da ponovo dele sobu. U 26 ...
23. 01. 2022.
Slučaj porodice Bošković, 25. i 26. spojene
Boškovići su normalni na srećan način. Srećne porodice su povremeno i nesrećne, i lude, i komplikovane. Ono što ih čini srećnim jeste da su funkcionalne u svojoj disfunkciji. Boškovići se vole, i to ih čini srećnim.
... , naravno, na Danijelu spada briga o njoj. Jovana i Velibor su primorani da ponovo dele sobu. U 26 ...
20. 01. 2022.
Slučaj porodice Bošković, 25. i 26. spojene
Boškovići su normalni na srećan način. Srećne porodice su povremeno i nesrećne, i lude, i komplikovane. Ono što ih čini srećnim jeste da su funkcionalne u svojoj disfunkciji. Boškovići se vole, i to ih čini srećnim.
... , naravno, na Danijelu spada briga o njoj. Jovana i Velibor su primorani da ponovo dele sobu. U 26 ...
18. 09. 2021.
Slučaj porodice Bošković, 25. i 26. spojene
Boškovići su normalni na srećan način. Srećne porodice su povremeno i nesrećne, i lude, i komplikovane. Ono što ih čini srećnim jeste da su funkcionalne u svojoj disfunkciji. Boškovići se vole, i to ih čini srećnim.
... , naravno, na Danijelu spada briga o njoj. Jovana i Velibor su primorani da ponovo dele sobu. U 26 ...
15. 09. 2021.
Slučaj porodice Bošković, 25. i 26. spojene
Boškovići su normalni na srećan način. Srećne porodice su povremeno i nesrećne, i lude, i komplikovane. Ono što ih čini srećnim jeste da su funkcionalne u svojoj disfunkciji. Boškovići se vole, i to ih čini srećnim.
... , naravno, na Danijelu spada briga o njoj. Jovana i Velibor su primorani da ponovo dele sobu. U 26 ...
16. 05. 2021.
Slučaj porodice Bošković, 25. i 26.ep.
Boškovići su normalni na srećan način. Srećne porodice su povremeno i nesrećne, i lude, i komplikovane. Ono što ih čini srećnim jeste da su funkcionalne u svojoj disfunkciji. Boškovići se vole, i to ih čini srećnim.
... , naravno, na Danijelu spada briga o njoj. Jovana i Velibor su primorani da ponovo dele sobu. U 26 ...
12. 05. 2021.
Slučaj porodice Bošković, 25. i 26.ep
Boškovići su normalni na srećan način. Srećne porodice su povremeno i nesrećne, i lude, i komplikovane. Ono što ih čini srećnim jeste da su funkcionalne u svojoj disfunkciji. Boškovići se vole, i to ih čini srećnim.
... , naravno, na Danijelu spada briga o njoj. Jovana i Velibor su primorani da ponovo dele sobu. U 26 ...
06. 10. 2023.
U klinču, 26-30, 2S
Pošto su Mira i Velja otputovali u banju, Milica konačno dobija priliku da radi šta želi, a njen život cveta jer može da se vrati treninzima u klubu ,,Velter”. Ipak, stvari ne idu po njenom planu, jer i Tadija je stekao samopouzdanje kao Veljina zamena, a Miličin plan o osveti Violeti se komplikuje. Komplikacije čekaju i Filipa i Vanju nakon što pristanu da rade za sumnjivu klijentelu i to sve zbog ostvarenja sna o renoviranju kafane ,,Trst”. Hoće li se rizik isplatiti?
11. 11. 2020.
Bajden: Sramota je to što Tramp ne priznaje rezultat izbora
Novoizabrani predsednik SAD Džozef Bajden izjavio je u utorak da je sramotno to što njegov republikanski protivkandidat i aktuelni predsednik Donald Tramp nije priznao rezultat izbora.
... imenima za bar neke pozicije u Kabinetu do Dana zahvalnosti, koji se obeležava 26. novembra. Bajden ...